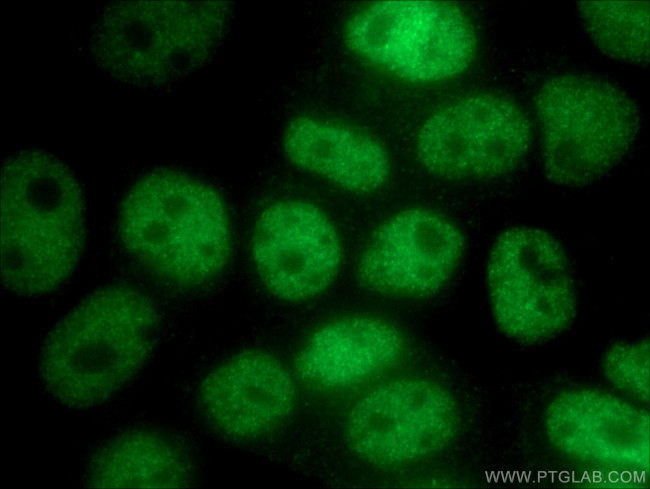
UBR5 Antibody in Immunocytochemistry (ICC/IF)

Search
Proteintech
UBR5 Polyclonal Antibody
{{$productOrderCtrl.translations['antibody.pdp.commerceCard.promotion.promotions']}}
{{$productOrderCtrl.translations['antibody.pdp.commerceCard.promotion.viewpromo']}}
{{$productOrderCtrl.translations['antibody.pdp.commerceCard.promotion.promocode']}}: {{promo.promoCode}} {{promo.promoTitle}} {{promo.promoDescription}}. {{$productOrderCtrl.translations['antibody.pdp.commerceCard.promotion.learnmore']}}
产品信息
22782-1-AP
种属反应
宿主/亚型
分类
类型
抗原
偶联物
形式
浓度
规格
纯化类型
保存液
内含物
保存条件
运输条件
产品详细信息
Aliquoting is unnecessary for -20°C storage.
靶标信息
EDD (for E3 identified by Differential Display) is a progestin-regulated gene that was isolated from T-47D human breast cancer cells. Based on sequence homology, EDD appears to be a human homolog of the Drosophila hyperplastic discs (hyd) gene, a tumor suppressor gene that is required for control of imaginal disc growth. EDD contains a HECT domain in the carboxy terminus. HECT domain-containing proteins function as ubiquitin-protein ligases, or E3 enzymes. EDD has been shown to bind to ubiquitin, and like other HECT family proteins, may function as an E3 ubiquitin-protein ligase.
仅用于科研。不用于诊断过程。未经明确授权不得转售。
生物信息学
蛋白别名: CH D1S3362; E3 identified by differential display; E3 ubiquitin-protein ligase UBR5; E3 ubiquitin-protein ligase, HECT domain-containing 1; ECGF1; EDG-1; EDG1; extraembryonic development; HECT E3; ubiquitin-protein ligase; HECT-type E3 ubiquitin transferase UBR5; hHYD; Hyperplastic discs protein homolog; Progestin-induced protein; S1P receptor 1; S1P receptor Edg-1; S1P1; S1PR1; unnamed protein product
基因别名: DD5; EDD; EDD1; HYD; KIAA0896; UBR5
UniProt ID: (Human) O95071, (Mouse) Q698K9
Entrez Gene ID: (Human) 51366, (Mouse) 70790